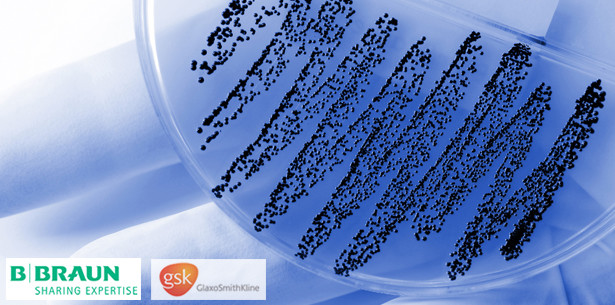
GlaxoSmithKline und B. Braun schließen Kooperation

Businessnews 22.05.2012
GlaxoSmithKline und B. Braun schließen Kooperation
GlaxoSmithKline GmbH & Co. (GSK) und die B. Braun Melsungen AG kooperieren bei der Bekämpfung multiresistenter Keime.
GlaxoSmithKline GmbH & Co. (GSK), eines der weltweit führenden forschenden Arzneimittel- und Healthcare-Unternehmen, und der weltweit tätige Medizintechnik- und Pharmahersteller B. Braun Melsungen AG kooperieren seit dem 15. Mai 2012 bei der Bekämpfung multiresistenter Keime wie MRSA. Für beide Partner bedeutet das Portfolio des jeweils anderen die ideale Ergänzung und somit eine logische Partnerschaft.
Wirksamkeit mit System
Aus den Produkten beider Firmen ergibt sich erstmals ein komplettes System aus einer Hand zur Sanierung von MRSA-Patienten: Turixin Nasensalbe mit dem Wirkstoff Mupirocin von GSK ist seit Jahren als Antibiotikum etabliert und wird vom Robert Koch-Institut zur Sanierung bei nasaler MRSA-Besiedlung empfohlen*. Zum Prontoderm-Programm von B. Braun, mit dem Inhaltsstoff Polihexanid, gehören ein Reinigungsschaum für die Haare, feuchte Waschtücher, eine Mundspüllösung, eine Lösung zur Ganzkörperwaschung – jeweils gebrauchsfertig oder als Konzentrat, sowie ein Duschgel. Zusammen angewendet, ermöglichen beide Produkte eine umfassende Eliminierung von MRSA-Keimen.
*N. Wischnewski, M. Mielke 2007. Übersicht über aktuelle Eradikationsstrategien bei Methicillinresistenten Staphylococcus aureus (MRSA) aus verschiedenen Ländern. Hyg Med 2007; 32 [10], 389
Ausbau der Zusammenarbeit
B. Braun wird künftig die Nasensalbe mit Mupirocin für die nasale MRSA-Sanierung in seinen Ratgebern und Fachunterlagen als Mittel der Wahl empfehlen. Weitere gemeinsame Aktivitäten, wie z. B. Netzwerkveranstaltungen, Messebeteiligungen, ein MRSA-Set und ein Film zum Thema MRSA sind in Planung. Der eigentliche Vertrieb von Turixin wird weiterhin direkt über GSK erfolgen.
MRSA-Management sind der Schlüssel zum Erfolg
Mit seiner Fachkompetenz in der MRE-Sanierung und Prophylaxe bringt B. Braun sein Know-how über den Aufbau von MRE-Netzwerken in die Kooperation ein und unterstützt Gesundheitseinrichtungen beim Aufbau des MRE-Managements. „Wir brauchen ein systematisches Hygienemanagement. Wenn sich alle Beteiligten im Gesundheitswesen abstimmen und offen über das Thema MRE kommunizieren, können wir viel erreichen“, sagt Peter Pfaff, Konzeptmanager für MRE-Projekte und Netzwerke bei B. Braun. „Denn MRE- und MRSA-Infektionen erhöhen die Morbidität und Mortalität betroffener Patienten, verlängern die Liegedauer und verursachen vermeidbare Kosten“, ergänzt Dr. Christof Ress, Medical Advisor bei GSK.
Über GlaxoSmithKline
GlaxoSmithKline ist ein weltweit führendes, forschendes Gesundheitsunternehmen, das sich der Entwicklung innovativer Arzneimittel verschrieben hat. Unser Anspruch ist es, die Lebensqualität von Menschen zu verbessern, indem wir ihnen ein aktives, längeres und gesünderes Leben ermöglichen. Der Patient steht im Mittelpunkt unserer Arbeit. GSK setzt Meilensteine bei Indikationen wie Atemwege, Dermatologie, Zentrales Nervensystem, Onkologie und Impfstoffe. In Deutschland ist der Bereich GSK Pharma an drei Standorten aktiv. Von der klinischen Entwicklung über die Produktion bis hin zum Vertrieb ist GSK eng mit dem Wirtschafts- und Wissenschaftsstandort Deutschland verbunden. Unsere medizinischen und wirtschaftlichen Erfolge verdanken wir dem beispielhaften Einsatz und Engagement unserer weltweit über 97.000 Mitarbeiter. Gesellschaftliche Verantwortung und Nachhaltigkeit sind Teil unserer Firmenphilosophie – wir fördern deshalb gezielt entsprechende Projekte in Deutschland und weltweit. GlaxoSmithKline hat seinen Hauptsitz in London und ist in über 100 Ländern der Welt tätig.